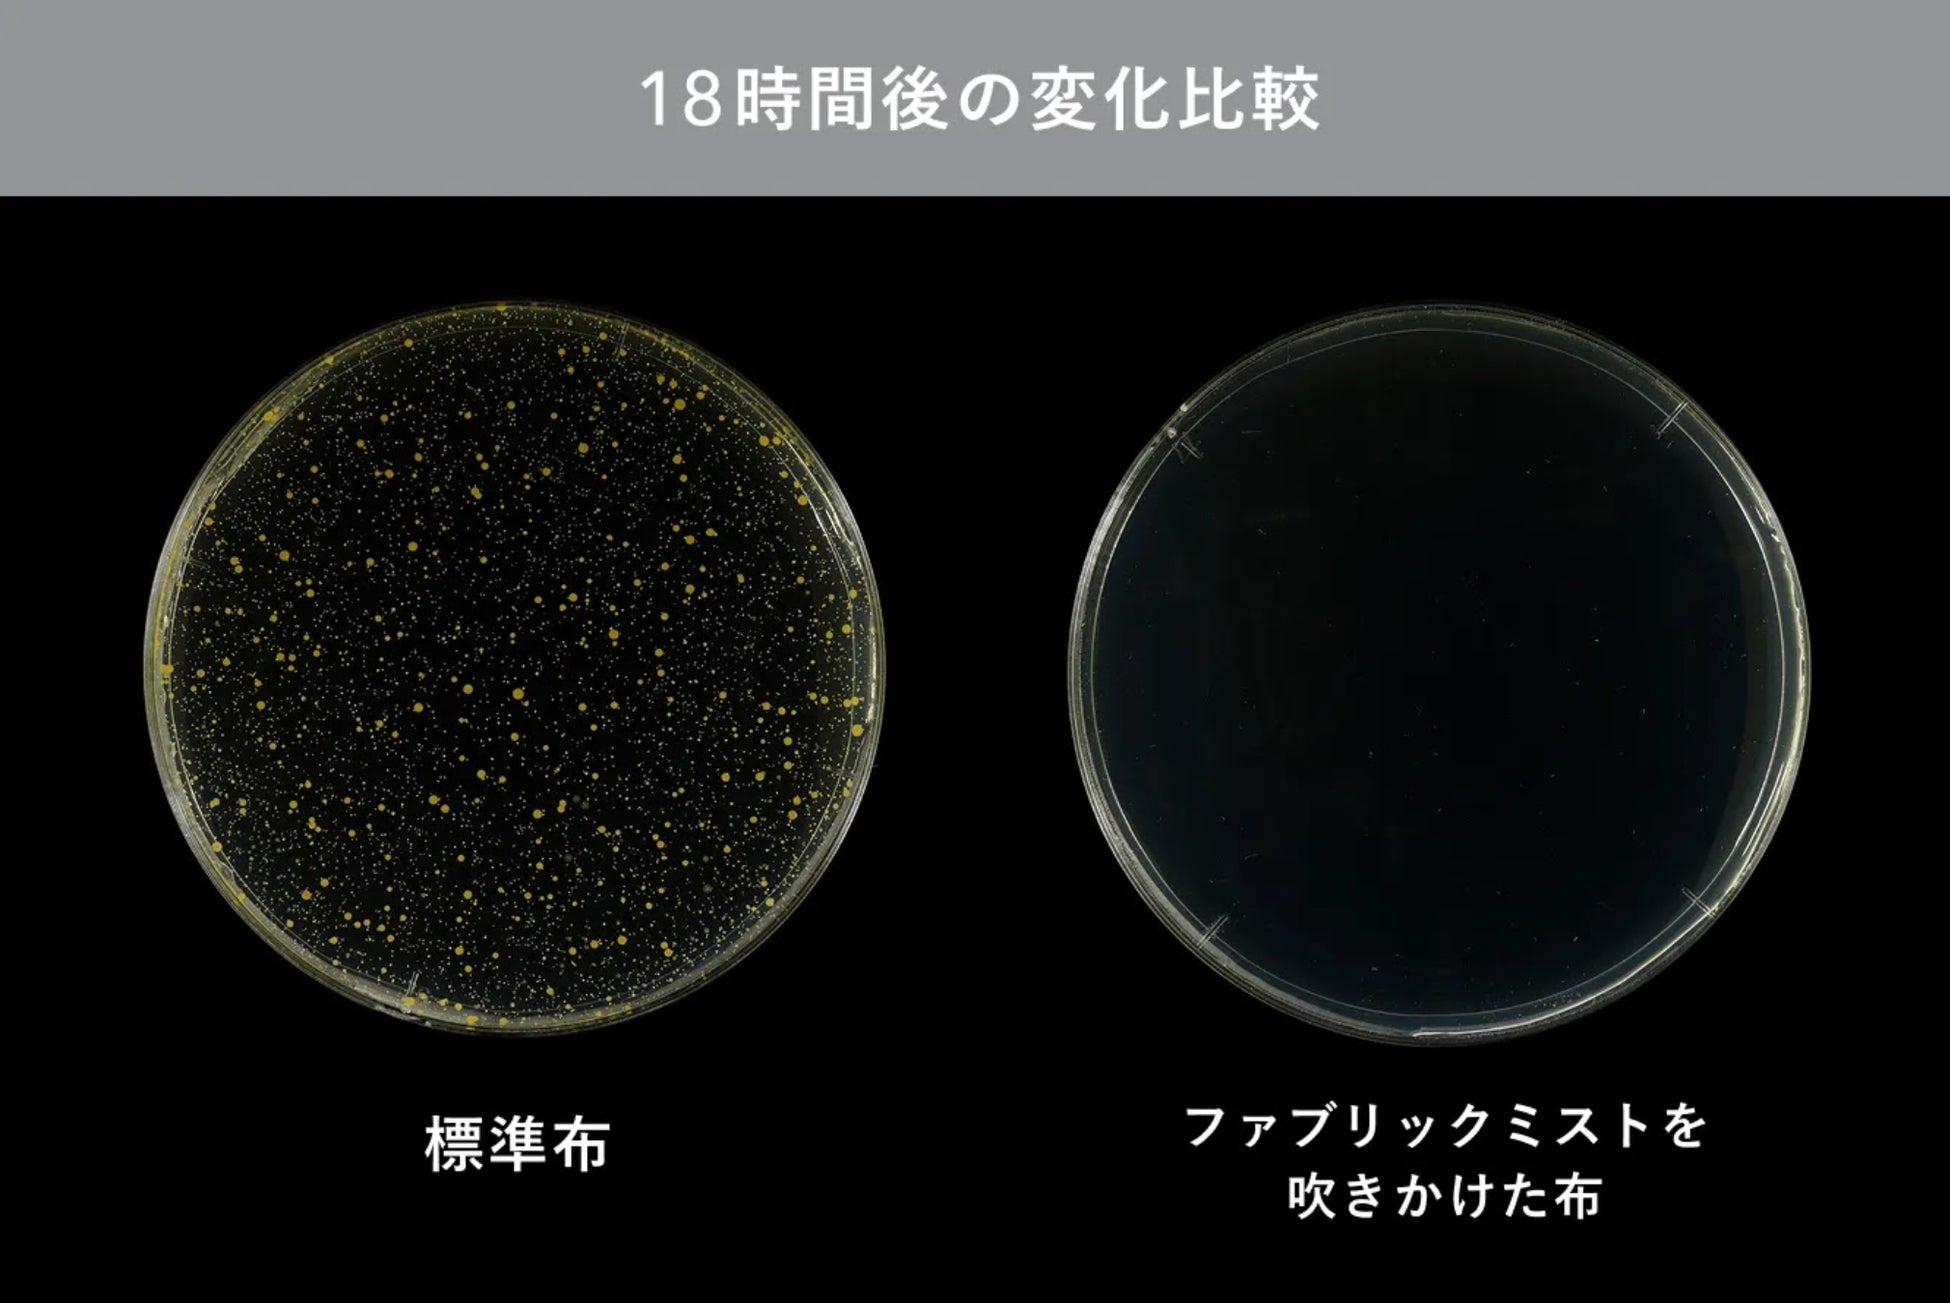

睡眠ブランドNELL、睡眠のためのメンテナンス商品「ファブリックミスト」を新発売 朝のひと吹きで寝具を清潔に
寝る時だけでなく“朝から寝る前までの過ごし方”をデザインする、新しい睡眠習慣を提案

睡眠ブランド 「NELL(ネル)」を展開する株式会社Morght(本社:東京都港区、代表取締役:土井皓貴、読み:モート) は、2025年10月9日(木)午前10時より“起きている時間帯”に使用する新カテゴリーとして初の“睡眠のためのメンテナンス商品”「NELL ファブリックミスト」 をNELL公式サイトにて発売いたします。
また、同日に、「じゃぶじゃぶ洗えて、羽毛布団クオリティ」の「NELL かけ布団」、「寝る10分前にスイッチひとつ」で睡眠環境の質向上が期待できる「NELL ふとん乾燥機」も発売いたします。
■NELLが掲げる「暮らしから始める睡眠革命」

NELLは、良質な睡眠を実現するためには、ベッドやマットレス単体の機能だけでは不十分であり、日々のライフルーティンを見直し、暮らしそのものを再設計することが必要だと考えています。
今回の「NELL ファブリックミスト」は、その思想を具現化するプロダクトの一つ。
朝、寝具にミストをひと吹きするだけで清潔な環境を整え、夜は自然な香りに包まれて入眠へ。
「朝のメンテナンスが夜の快眠へとつながる」──それがNELLが提案する新しい睡眠習慣です。
■開発ストーリー:寝具の「清潔を保てない問題」に、睡眠ブランドが本気で向き合う
NELLが行ったユーザーアンケート(n=508)では、約7割が「寝具の衛生状態が気になる」と回答。
特にマットレスは洗えないため、汚れや臭いに悩む声が多く寄せられました。
また、NELLユーザーへのインタビュー(n=8)では「市販の除菌・消臭スプレーは成分が強そうで肌に触れる寝具に使うのをためらう」という強い声(n=3)も半数近く寄せられたことに着目しました。
寝具に直接触れることを考えると、成分への安心感が求められていることが分かり、寝具を提供している睡眠ブランド独自目線での開発が必要だと考えました。
こうした声を受け、NELLは「夜の睡眠ケアだけでなく、朝〜夜の過ごし方そのものを設計することで睡眠環境の質を高める」という新しい発想のもと、“起きている時間に使う”睡眠プロダクト=活動中プロダクトの第一弾として、ファブリックミストを開発しました。
■商品特徴:「NELL ファブリックミスト」が叶える“1日をととのえる眠りの設計”

①高い「抗菌・消臭・防カビ」効果
抗菌率は99.9%以上※1。また、消臭効果は最大90%※2。 寝具に付着しがちな汗臭、加齢臭、アンモニア臭にしっかり対応します。
※1 JIS L 1902 繊維製品の抗菌性試験方法及び抗菌効果
※2 布自体および時間経過による自然消臭効果を含む。第三者機関による試験結果による
② 肌にやさしい「肌フレンドリー成分」配合
抗菌・消臭・防カビなどの基本効果を備えながら植物由来成分を95%以上配合。
毎日使う寝具に安心して使用できるよう、肌へのやさしさを徹底的に追求しました。
③ 朝から夜まで香りが変化する“眠りを計算した香り設計”
朝、吹きかけた瞬間はグレープフルーツやレモンの爽やかな香り。
夜、眠る頃にはシダーウッドやムスクの落ち着いた香りがほのかに香るよう設計されています。
「朝から夜まで」一日を通して心身をととのえる睡眠ブランドならではの香りのグラデーションです。
④ NELLユーザーとともに生まれた香り
開発段階では、「NELL」の愛用者や睡眠にこだわりをもつユーザーが試香し、実際のフィードバックを反映。「香りが睡眠環境の質に寄り添うかどうか」を基準に、繊細なブレンドを重ねて完成しました。
■商品概要
・ 商品名 :NELL ファブリックミスト
・発売日:2025年10月9日(木)午前10:00
・発売場所:NELL公式オンラインストア(https://nell.life/products/fabric-mist)
・内容量:300mL(1日3プッシュで約3ヶ月分ご使用いただけます)
・価格:2,300円(税込)
・主成分:植物由来成分95%以上配合(抗菌・消臭・防カビ効果)
・香り:
朝:グレープフルーツ&レモン/夜:シダーウッド&ムスク
■今後の展望
睡眠ブランド「NELL」は、“ライフルーティンの再設計”をテーマにした睡眠環境改善プロダクトを今後も発表・展開していきます。
「良い睡眠は夜だけでつくられるものではない」──NELLは、長年にわたる“寝返り”の研究を通じて、快適な睡眠は一日の過ごし方=日中の習慣そのものに深く関係しているという結論に至りました。
マットレスにとどまらない、新しい「眠りの整え方」。
共働き世代や慢性的な疲労を抱える現代人に向けて、生活の中に無理なく取り入れられる“ルーティン設計型プロダクト”を通じた新しいアプローチを順次お届けします。
「NELL」の「ルーティン設計型プロダクト」は今後とも拡大予定です。ぜひお楽しみに。
■「睡眠休養感」を向上させる睡眠ブランド「NELL」について

2020年10月にスタートした、D2C睡眠ブランドです。睡眠の本質を「準備」と捉え、生活者が睡眠時間以外の生活において最高のパフォーマンスを発揮できるように、「質の高い準備=睡眠」を提供することを目的に、製品の研究・開発を行っています。
・公式サイト
■睡眠メディア「WENELL(ウィーネル)」について

「WENELL(ウィーネル)」は、睡眠にかかわる悩みを感じているすべての方々へ向けて、解決のヒントとなるような有益な情報を網羅的にお届けすることで、様々な悩みの解決・緩和の一助になりたい、というアイデアからスタートしました。「WENELL(ウィーネル)」がお届けする情報をもとに色々なアクションをお試しいただきながら、ご自身にあった寝具やルーティンを見つけていただきたいと考えています。
・WENELL
■株式会社Morght 会社概要
設立:2018年5月23日
代表者:代表取締役 土井皓貴
事業内容:D2C睡眠ブランド「NELL」製品の企画・販売
本社:東京都港区南青山3-1-34 3rd MINAMI AOYAMA6F
資本金:3,312万円
・会社ホームページ
・公式Instagram
https://www.instagram.com/nell_mattress/
・公式X(旧Twitter)
https://twitter.com/NELL_mattress
・睡眠メディア「WENELL(ウィーネル)」
このプレスリリースには、メディア関係者向けの情報があります
メディアユーザー登録を行うと、企業担当者の連絡先や、イベント・記者会見の情報など様々な特記情報を閲覧できます。※内容はプレスリリースにより異なります。
すべての画像
